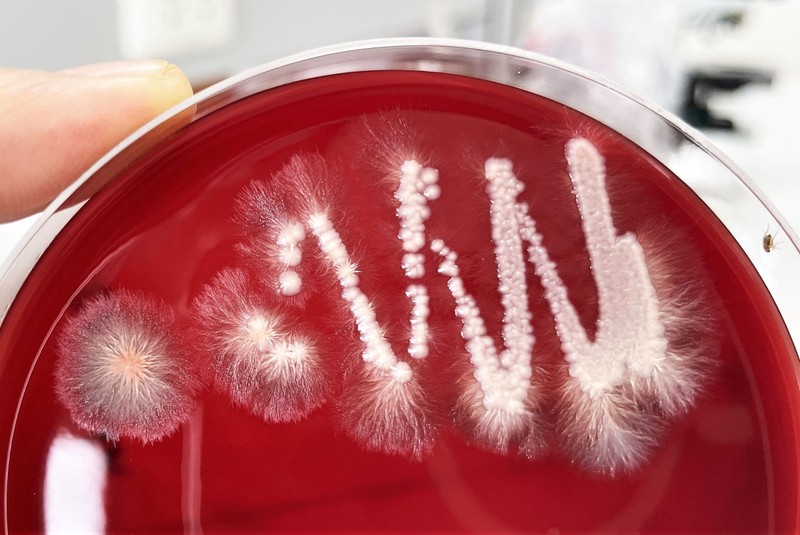
Candida-fertőzésre gyanakszik? Ezzel a módszerrel derítheti ki biztosan!

Candida diéta

Candida: ez az igazi veszélye a gomba elszaporodásának a bélben
Vajon érdemes belevágni a Candida-diétába?
Candida-fertőzésre gyanakszik? Ezzel a módszerrel derítheti ki biztosan!
Évekkel ezelőtt úgy tekintettek a Candida albicans élesztőgombára, mint számos panasz okára. Ma már másként értékelik a „gombás” állapotot, és másként zajlik a kezelése is.

Nem (csak) a Candida-diéta, hanem a jól megválasztott kezelés segíthet! (x)
A hüvelygomba ellen számos „házi praktika” létezik, ám ezek között több olyan is akad, amelynek igencsak kétes a hatásossága. Lehet, hogy meglepően hangzik, de a tudományos megalapozottság szempontjából a népszerű „Candida-diéta” is meglehetősen gyenge lábakon áll.

Hasznos tippek: így előzzük meg a hüvelygombát
A hüvelygomba rengeteg nő életét megkeseríti. Az égő, viszkető érzés a mindennapokat is megnehezíti, ezért összegyűjtöttünk néhány hasznos tanácsot és tippet, ami segíthet abban, hogy elkerüljük a hüvelygomba kialakulását.

Gyilkos japán hónaljgomba pusztít a kórházakban
Angliában már 8 emberrel végzett egy japánból származó gombafaj, a Candida auris - jelent meg a Mirror oldalán.